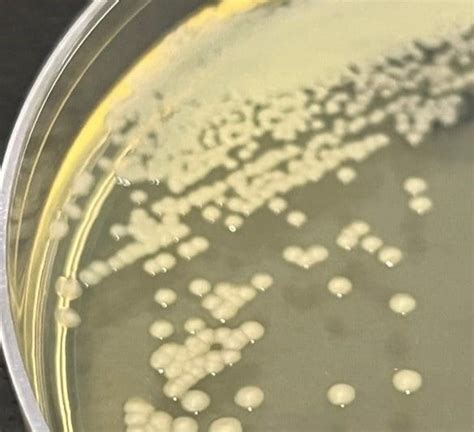

Understanding Lmzh Pseudomonas Fluorescens
Understanding lmzh Pseudomonas fluorescens
Let’s dive deep into understanding lmzh Pseudomonas fluorescens . This bacterium, part of the larger Pseudomonas genus, is incredibly versatile and plays significant roles in various environments. We’ll explore its characteristics, its impact on agriculture, its presence in soil, and its potential applications. Understanding lmzh Pseudomonas fluorescens not only enriches our knowledge of microbiology but also opens doors to innovative solutions in diverse fields. So, buckle up, guys, and let’s get started on this fascinating journey!
Table of Contents
What is Pseudomonas fluorescens ?
Pseudomonas fluorescens is a common, non-pathogenic bacterium that belongs to the Pseudomonas genus. It’s found in soil, water, and on plant surfaces worldwide. This bacterium is known for its diverse metabolic capabilities and its ability to produce a fluorescent pigment called pyoverdine, which gives it a greenish-yellow appearance under UV light. Pseudomonas fluorescens is a Gram-negative, rod-shaped bacterium that thrives in aerobic environments, meaning it requires oxygen to survive. However, it can also grow in anaerobic conditions if nitrate is available as an alternative electron acceptor. Its adaptability allows it to colonize various ecological niches, making it a ubiquitous presence in many ecosystems.
One of the key features of Pseudomonas fluorescens is its role in agriculture. It acts as a biocontrol agent, protecting plants from fungal and bacterial pathogens. It achieves this through several mechanisms, including the production of antimicrobial compounds, competition for resources with pathogens, and the induction of systemic resistance in plants. This makes Pseudomonas fluorescens a valuable tool in sustainable agriculture, reducing the need for synthetic pesticides and promoting healthier plant growth. Furthermore, it enhances nutrient availability in the soil, promoting overall soil health and fertility. This bacterium also contributes to bioremediation, helping to clean up contaminated environments by breaking down pollutants.
Pseudomonas fluorescens produces a variety of secondary metabolites, including antibiotics, siderophores, and enzymes. These compounds contribute to its biocontrol activity and its ability to survive in different environments. The production of pyoverdine, a siderophore, is particularly important for iron acquisition, an essential nutrient for bacterial growth. Iron is often limited in the environment, and pyoverdine helps Pseudomonas fluorescens scavenge iron from its surroundings, giving it a competitive advantage over other microorganisms. In addition to pyoverdine, Pseudomonas fluorescens produces other siderophores, such as pseudobactin, which also play a crucial role in iron uptake. The bacterium’s ability to produce a wide range of antimicrobial compounds, including antibiotics like oomycin A and 2,4-diacetylphloroglucinol (DAPG), inhibits the growth of many pathogenic fungi and bacteria. These compounds disrupt the cell walls or metabolic processes of the pathogens, effectively controlling their spread and protecting plants from disease. The production of enzymes, such as chitinases and proteases, further enhances its biocontrol capabilities by breaking down the cell walls of fungi and the proteins of other microorganisms. All these compounds make Pseudomonas fluorescens a potent and versatile biocontrol agent, offering a sustainable and environmentally friendly alternative to chemical pesticides.
Role in Agriculture
In agriculture, the role of Pseudomonas fluorescens is multifaceted. First and foremost , it serves as a potent biocontrol agent, protecting crops from various fungal and bacterial diseases. This bacterium colonizes plant roots and produces a range of antimicrobial compounds that inhibit the growth of soilborne pathogens. By competing with harmful microorganisms for nutrients and space, Pseudomonas fluorescens reduces the incidence of plant diseases, leading to healthier and more productive crops. The use of Pseudomonas fluorescens as a biocontrol agent is particularly beneficial in sustainable agriculture, where the reduction of synthetic pesticides is a priority. The bacterium’s natural ability to suppress pathogens makes it an environmentally friendly alternative to chemical treatments, minimizing the impact on beneficial organisms and reducing the risk of pesticide resistance.
Secondly , Pseudomonas fluorescens enhances plant growth by improving nutrient availability in the soil. It solubilizes phosphates, converting them into a form that plants can easily absorb. Phosphorus is an essential nutrient for plant growth, playing a crucial role in energy transfer, photosynthesis, and root development. However, much of the phosphorus in the soil is in an insoluble form that plants cannot utilize. Pseudomonas fluorescens produces enzymes and organic acids that dissolve these insoluble phosphates, making them available to plants. This improves plant nutrition, leading to increased growth rates and higher yields. Moreover, Pseudomonas fluorescens produces siderophores, which bind to iron and make it more accessible to plants. Iron is another essential nutrient that is often limited in the soil, particularly in alkaline conditions. Siderophores produced by Pseudomonas fluorescens chelate iron, preventing it from being locked up in insoluble forms and facilitating its uptake by plant roots. This enhances iron nutrition, preventing iron deficiency and promoting healthy plant growth.
Thirdly , Pseudomonas fluorescens induces systemic resistance in plants, boosting their defense mechanisms against pathogens. Systemic resistance is a phenomenon where plants become more resistant to a wide range of diseases after being exposed to certain beneficial microorganisms. Pseudomonas fluorescens triggers this response by activating the plant’s defense signaling pathways. When the bacterium colonizes plant roots, it releases signal molecules that are recognized by the plant’s immune system. This triggers a cascade of defense responses, including the production of antimicrobial compounds, the strengthening of cell walls, and the activation of defense-related genes. As a result, plants become more resistant to subsequent infections by pathogens, reducing the severity of diseases and improving overall plant health. The induction of systemic resistance is a long-lasting effect, providing plants with sustained protection against diseases throughout their life cycle. The bacterium not only protects plants from diseases but also promotes their overall health and vigor. Its ability to enhance nutrient availability, induce systemic resistance, and act as a biocontrol agent makes it an invaluable tool for sustainable agriculture, contributing to healthier and more productive crops.
Presence in Soil
Pseudomonas fluorescens thrives in the soil, making it a crucial component of the soil microbiome. Its presence is influenced by various factors, including soil type, moisture levels, temperature, and the availability of nutrients. Understanding these factors helps us appreciate its role in maintaining soil health. It’s commonly found in the rhizosphere, the area of soil directly influenced by plant roots, where it interacts closely with plant roots and other microorganisms. This bacterium is also present in bulk soil, away from plant roots, although its population density may be lower in these areas. The bacterium’s ability to adapt to diverse environmental conditions allows it to colonize different soil types, from sandy soils to clay soils. Pseudomonas fluorescens prefers moist soil conditions, as water is essential for its growth and survival. The bacterium requires a certain level of water availability to maintain its cellular functions and transport nutrients. However, it can also tolerate periods of drought by forming biofilms, which protect it from desiccation.
Temperature is another critical factor that influences the presence and activity of Pseudomonas fluorescens in the soil. It grows optimally at temperatures between 25°C and 30°C, although it can also grow at lower temperatures, albeit at a slower rate. High temperatures, above 35°C, can inhibit its growth and even kill the bacterium. Nutrient availability is also a key determinant of its population size. Pseudomonas fluorescens requires carbon, nitrogen, phosphorus, and other essential nutrients for its growth and metabolism. The availability of these nutrients in the soil depends on factors such as organic matter content, fertilization practices, and the activity of other microorganisms. Soils rich in organic matter tend to support larger populations of Pseudomonas fluorescens , as organic matter provides a source of carbon and other nutrients. Fertilization with nitrogen and phosphorus can also enhance the growth of Pseudomonas fluorescens , particularly in soils that are deficient in these nutrients.
The presence of Pseudomonas fluorescens in the soil has numerous beneficial effects on soil health and plant growth. As we’ve discussed, it acts as a biocontrol agent, protecting plants from soilborne pathogens, enhances nutrient availability by solubilizing phosphates and chelating iron, and induces systemic resistance in plants, boosting their defense mechanisms. In addition to these direct effects , Pseudomonas fluorescens also contributes to soil structure and stability. It produces exopolysaccharides, which are sticky substances that bind soil particles together, improving soil aggregation and reducing erosion. Soil aggregation is important for maintaining soil porosity, which allows for better water infiltration and aeration. This enhances root growth and nutrient uptake by plants. It also plays a role in the decomposition of organic matter, releasing nutrients that can be used by plants and other microorganisms. It produces enzymes that break down complex organic compounds, such as cellulose and lignin, into simpler forms that can be easily assimilated. This helps to recycle nutrients in the soil, promoting soil fertility and sustainability. The presence of Pseudomonas fluorescens in the soil is essential for maintaining soil health and supporting plant growth. Its diverse metabolic capabilities and its ability to interact with plants and other microorganisms make it a valuable component of the soil microbiome, contributing to a healthy and sustainable ecosystem.
Potential Applications
The potential applications of Pseudomonas fluorescens extend beyond agriculture, encompassing bioremediation, industrial processes, and even medical applications. Its versatility and adaptability make it a valuable tool in various fields. First and foremost , it is used in bioremediation to clean up contaminated environments. It can degrade a wide range of pollutants, including petroleum hydrocarbons, pesticides, and heavy metals. This bacterium breaks down these pollutants into less harmful substances, effectively detoxifying the environment. It achieves this through several mechanisms, including the production of enzymes that degrade pollutants, the uptake and accumulation of pollutants in its cells, and the stimulation of other microorganisms that contribute to pollutant degradation. The use of Pseudomonas fluorescens in bioremediation is particularly attractive because it is a natural and environmentally friendly approach to cleaning up contaminated sites. The bacterium can be applied directly to the soil or water, where it will begin to degrade the pollutants without causing any further harm to the environment. Its ability to thrive in diverse environmental conditions makes it suitable for bioremediation in a wide range of settings, from contaminated industrial sites to agricultural lands polluted with pesticides.
Secondly , Pseudomonas fluorescens is used in various industrial processes, including the production of enzymes, bioplastics, and other valuable compounds. It can be engineered to produce specific enzymes that are used in various industries, such as the food, textile, and pharmaceutical industries. These enzymes can be used to catalyze a wide range of reactions, from the breakdown of starch in the food industry to the removal of stains in the textile industry. The bacterium can also be used to produce bioplastics, which are biodegradable alternatives to traditional plastics. Bioplastics are made from renewable resources, such as plant starches or vegetable oils, and they can be broken down by microorganisms in the environment, reducing the accumulation of plastic waste. The use of Pseudomonas fluorescens to produce bioplastics is a promising approach to reducing our reliance on fossil fuels and minimizing the environmental impact of plastics. In addition, it can be used to produce other valuable compounds, such as biosurfactants and pigments, which have various applications in the cosmetic, pharmaceutical, and food industries.
Thirdly , Pseudomonas fluorescens has potential medical applications, including the development of novel antibiotics and probiotics. It produces a range of antimicrobial compounds that can be used to treat bacterial infections. These compounds have a different mechanism of action than traditional antibiotics, making them effective against bacteria that have developed resistance to existing drugs. The development of new antibiotics from Pseudomonas fluorescens is a promising approach to combating antibiotic resistance, a growing threat to public health. It can also be used as a probiotic to promote gut health. Probiotics are live microorganisms that, when administered in adequate amounts, confer a health benefit on the host. It can colonize the gut and produce beneficial compounds, such as short-chain fatty acids, which promote the growth of beneficial bacteria and inhibit the growth of harmful bacteria. The use of Pseudomonas fluorescens as a probiotic may help to improve gut health, boost the immune system, and prevent various diseases. The diverse applications of Pseudomonas fluorescens highlight its potential as a valuable resource for various industries and fields. Its ability to degrade pollutants, produce valuable compounds, and promote human health makes it a promising tool for addressing some of the most pressing challenges facing society today.
In conclusion, Pseudomonas fluorescens is a fascinating and versatile bacterium with significant implications for agriculture, bioremediation, and various industrial processes. Its ability to act as a biocontrol agent, enhance nutrient availability, and promote plant growth makes it an invaluable tool for sustainable agriculture. Furthermore, its role in bioremediation and its potential medical applications highlight its broader significance in addressing environmental and health challenges. As research continues, we can expect to uncover even more ways to harness the power of Pseudomonas fluorescens for the benefit of society and the environment. Keep exploring, guys!